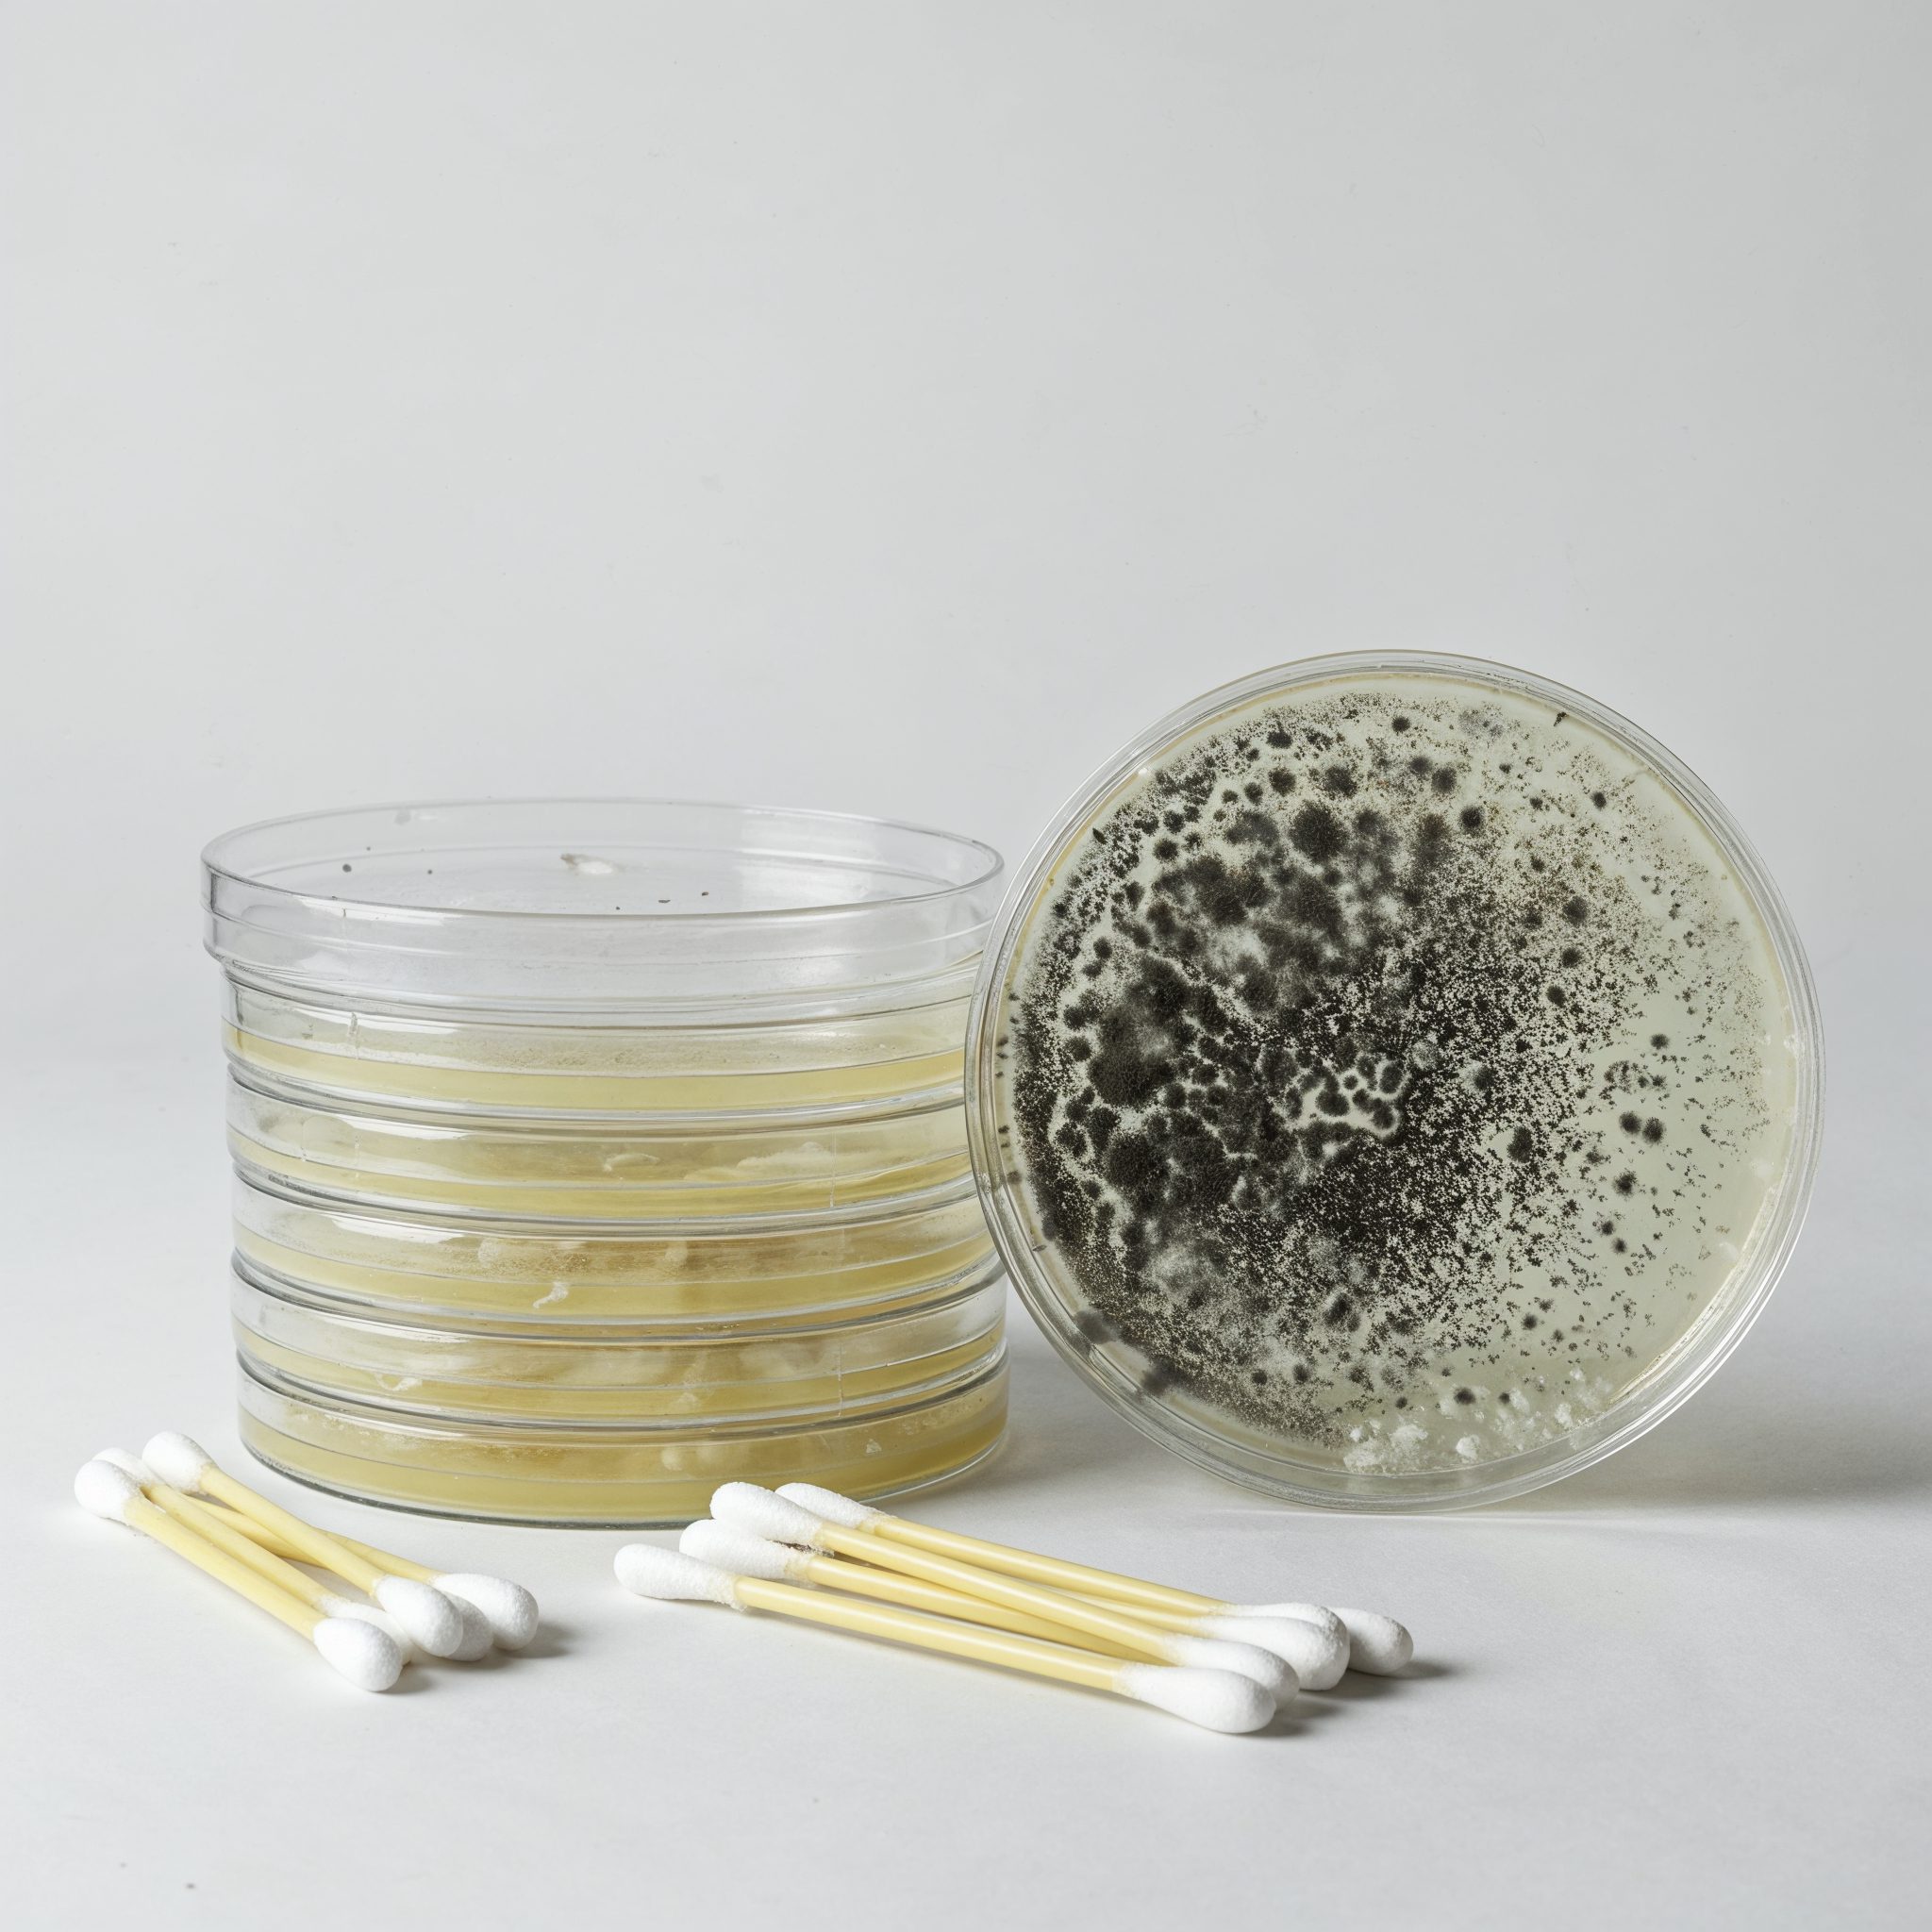
mold petri dish

Black Mold vs Toxic Mold: 7 Critical Differences to Know
Mold is a common household issue, but not all molds are created equal—understanding the differences between black mold vs toxic mold can protect your home and health. Many people encounter black mold in shower areas or black mold in bathroom spaces, often mistaking it for something more dangerous due to its dark appearance. At Teton Environmental, we emphasize the importance of mold inspection and testing to identify what’s growing in your home—because mold exposure can cause severe health risks, including respiratory issues and allergies.
Knowing whether you’re dealing with black mold or toxic mold can make all the difference.
What Is Black Mold vs Toxic Mold? Understanding the Basics
When discussing black mold vs toxic mold, it’s critical to clarify that “black mold” often refers to Stachybotrys chartarum, a specific type known for its dark, slimy appearance. However, not all black mold is toxic, and types of toxic mold include other species like Aspergillus or Penicillium, which may not always be black but can produce harmful mycotoxins. Unlike black mold, regular mold which might just be an aesthetic nuisance, toxic mold poses serious health risks—oh, and yes, does black mold smell? It often does, with a musty odor that’s hard to ignore.
Check out the Teton Environmental blog for more insights on mold basics.
Not all molds are toxic, but all toxic molds can harm you if left unchecked.
The 7 Key Differences Between Black Mold vs Toxic Mold
Understanding black mold vs toxic mold involves recognizing their distinct traits, from toxicity to appearance. While black mold vs regular mold might seem like a simple comparison, toxic molds elevate the stakes with health implications, especially for vulnerable groups like infants. For example, black mold symptoms in babies and black mold symptoms in infants can include coughing or skin irritation, making identification crucial.
Let’s break down these differences to keep your home safe.
1. Black Mold vs Toxic Mold Toxicity Levels: Which Mold Is More Dangerous?

The debate over black mold vs toxic mold often centers on toxicity—Stachybotrys (black mold) is infamous for mycotoxins, but other types of toxic mold can be just as harmful. Questions like can black mold cause cancer or does black mold cause cancer arise, though evidence is inconclusive; still, prolonged exposure, especially to black mold in walls, is risky. Learn more about interpreting mold dangers with Mold Test Results: 5 Key Steps to Understand Them.
Toxicity varies, but both can be hazardous if ignored.
2. Common Locations for Black Mold vs Toxic Mold in Homes
When comparing black mold vs toxic mold, location matters—black mold in bathroom areas, black mold on ceiling, or black mold in basement thrives in damp, dark spots. Toxic molds might appear elsewhere but share a love for moisture, often popping up alongside black mold on window sills. These spots signal poor ventilation or leaks, making inspection a must.
Moisture is the common thread for mold growth.
3. Health Risks: How Mold Affects Your Body
Health effects differ in black mold vs toxic mold, but both can trigger issues—black mold symptoms in babies and black mold symptoms in infants might mimic allergies, while adults face respiratory woes. The question does black mold cause cancer lingers, but documented risks include asthma and infections. Vulnerable populations need extra caution around any mold exposure.
Mold isn’t just unsightly—it’s a health hazard.
4. Texture & Color: How to Tell the Difference Visually
Visually, black mold vs green mold is obvious—black mold is dark and slimy, while toxic molds vary in hue. Black mold in air conditioner unit or black mold on windows might look menacing, but what does harmless black mold look like? It’s typically dry and powdery, less threatening than its slimy toxic cousins.

Color and texture offer clues to mold type.
What Does Black Mold vs Toxic Mold Look Like? Signs to Watch For
Distinguishing black mold vs regular mold or black mold vs toxic mold involves scrutiny—toxic molds might be fuzzy, while harmless black mold stays flat. Look for slimy patches on black mold on drywall or in an black mold in apartment setting as a red flag. What does harmless black mold look like? It’s less aggressive visually, lacking that wet sheen.
Visual identification is your first defense.
5. Smell: Does Black Mold Have a Smell?
A frequent query is does black mold have a smell—yes, black mold smell is musty and damp, a telltale sign in places like black mold in vents or black mold in air ducts. In black mold vs toxic mold, odor intensity varies, but both can stink up a space. Smell often betrays hidden mold before you see it.
Your nose can detect mold before your eyes do.
What Does Black Mold vs Toxic Mold Smell Like? How to Identify by Odor
Curious about what does black mold smell like? It’s earthy and stale, especially in black mold in air vents, where airflow spreads the black mold smell. Does black mold have a smell that differs from black mold vs toxic mold? Not drastically—both signal trouble with a pungent kick.
Odor is a key identifier for mold presence.
6. Growth Conditions: What Causes Black Mold to Spread?
Black mold vs toxic mold thrives in wet conditions—think black mold in washing machine, black mold in water bottle, or black mold in toilet. Poorly cleaned black mold on carpet also fosters growth, feeding on moisture and neglect. These molds spread where water lingers, making prevention a priority.

Control moisture, control mold.
7. Removal Methods: How to Get Rid of Mold Safely
Removing black mold vs toxic mold requires care—how to remove black mold from walls starts with protective gear and ventilation. Does bleach kill black mold? It can, but what kills black mold on wood might need vinegar or professional help—then, how to dispose of black mold safely avoids spreading spores.
Safe removal protects your home and lungs.
Why It’s Important to Know about Black Mold vs Toxic Mold in Your Home
Awareness of black mold vs toxic mold isn’t just academic—it’s a health imperative, especially when black mold vs regular mold hides in plain sight. Black mold symptoms in babies and black mold symptoms in infants underscore the stakes for families. Ignoring mold risks costly repairs and illness.
Knowledge is your shield against mold dangers.
Best Kits & Services for Mold Inspection & Testing
Unsure about black mold vs toxic mold in your home? A mold testing kit or home mold testing kit from Teton Environmental offers clarity—read Do mold testing kits really work for proof. Pair it with mold inspection services near me or an asbestos testing service for comprehensive safety.
-
Mold Test Kit – Lab Fees Included, 1 Swab can Detect 20+ Mold Types & Pollen, Easy-to-Use Guide, Professional-Grade Testing
Price range: $54.95 through $124.95Mold Test Kit – Professional-Grade Mold Testing Made Easy Uncover hidden mold and protect your health with the Teton Environmental Mold Test Kit—your…
Testing empowers you to act decisively.
How to Prevent Black Mold vs Toxic Mold in Your Home
Preventing black mold vs toxic mold starts with ventilation—black mold in air conditioner or black mold in bathtub hates dry, airy spaces. Regular cleaning black mold in shower and checking black mold in the shower keeps growth at bay. Fix leaks fast to starve mold of moisture.
Prevention beats cure every time.
Protect Your Home and Family with Teton Environmental
With black mold vs toxic mold lurking, Teton Environmental offers home environmental testing and mold inspection and testing to safeguard your space. Wondering how to dispose of black mold? Contact Teton Environmental for expert help and peace of mind.
Your family deserves a mold-free home.
FAQs About Black Mold vs Toxic Mold
Got questions about black mold vs toxic mold? From does black mold cause cancer to spotting black mold in air conditioner unit or black mold on drywall, we’ve got answers. Here’s what you need to know.
Can black mold cause cancer?
Research on does black mold cause cancer is mixed—no direct link exists, but mycotoxins raise concerns. Long-term exposure might worsen other conditions, though. Consult a doctor if worried.
Is black mold in shower dangerous?
Yes, is black mold in shower dangerous depends on extent—small patches annoy, but heavy black mold in shower growth risks health. Act fast to clean it.
What kills black mold on wood?
For what kills black mold on wood, vinegar or hydrogen peroxide work—scrub thoroughly. Avoid bleach on porous surfaces; it’s less effective. Pros can handle big jobs.
How to remove black mold from walls?
How to remove black mold from walls starts with gloves, a mask, and a scrub brush—use detergent or vinegar. Ventilate well and dry completely. Dispose of debris in sealed bags.
FAQs clarify mold mysteries.
FAQs About Teton Environmental
Need mold inspection services near me or home environmental testing? Teton Environmental excels in mold inspection and testing and environmental house inspection. Here’s the scoop.
What services does Teton Environmental offer?
Teton provides mold inspection and testing, plus more. They tackle diverse threats with expertise. Your home’s safety is their mission.
Asbestos Testing Service
Check out Asbestos testing for hidden dangers.
Lead Inspection
Lead testing ensures no toxic surprises.
Water Testing Services
Water testing keeps your supply pure.
Erosion Control Services
Erosion control protects your property.
How do I know if I need mold testing in my home?
Musty smells or black mold vs toxic mold sightings signal a need for testing. Health issues like allergies might too. A home mold testing kit confirms suspicions.
What areas does Teton Environmental provide services for?
Teton serves wide regions—check Contact Teton Environmental for specifics. They’re ready to assist. Coverage varies, so inquire.
Can Teton Environmental help with asbestos testing services?
Yes, their Asbestos testing service is top-notch. They identify and advise. Safety is guaranteed.
Teton Environmental is your home’s ally.
Contact
Ready to schedule your mold inspection or have questions? Fill out the form below and we will get back with you.